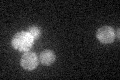
YGR198W

View description
Cargo-transport protein involved in endocytosis; interacts with phosphatidylinositol-4-kinase Stt4; GFP-fusion protein localizes to the cytoplasm; YGR198W is an essential gene
Localization:
Intensity:
Fold change:
Significance:
-
C’ GFP library in SD

punctate26.19 -
N' NOP1pr-GFP in SD

cytosol,nucleus72.3872 -
N' TEF2pr-mCherry in SD

cytosol,nucleus52.488 -
N' NATIVEpr-GFP in SD

cell periphery,punctate26.3949 -
N' TEF2pr-VC and Cyto-VN in SD

cytosol37.216 -
C’ GFP library in SD+DTT

punctate26.31No -
C’ GFP library in SD+H2O2
punctate29.531.12No -
C’ GFP library in Starvation Media

punctate19.040.72Yes -
C’ GFP library on the background of Pup2-DaMP

punctate -
C’ GFP library on the background of CCT mutant

punctate28.4981.08792No
